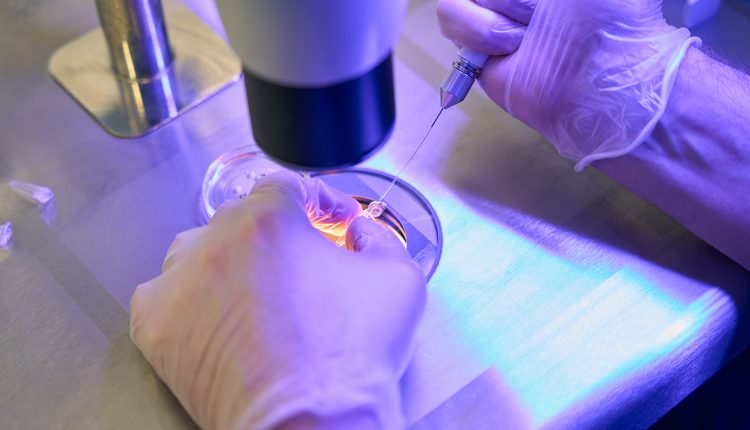
Η-επιδημία-της-ιλαράς-κλιμακώνεται-στην-Αμερική,-προειδοποιούν-ειδικοί-ενόψει-του-παγκόσμιου-κυπέλλου-ποδοσφαίρου

Η επιδημία της ιλαράς κλιμακώνεται στην Αμερική, προειδοποιούν ειδικοί ενόψει του παγκόσμιου κυπέλλου ποδοσφαίρου
Για την κλιμάκωση της επιδημίας της ιλαρά στην αμερικανική ήπειρο προειδοποίησε ο Παναμερικανικός Οργανισμός Υγείας (ΠΑΟΥ) την Πέμπτη, καθώς πλησιάζει το παγκόσμιο κύπελλο ποδοσφαίρου που ξεκινά τον Ιούλιο στις ΗΠΑ, στο Μεξικό και στον Καναδά.
Τα κρούσματα ιλαράς που καταγράφονται στην ήπειρο βρίσκονται σε καθαρή άνοδο από το 2025, κυρίως στις χώρες της βόρειας Αμερικής, όπου ουδέποτε εξαλείφθηκε η εξαιρετικά μολυσματική και δυνητικά θανατηφόρα ασθένεια.
Την περασμένη χρονιά, καταγράφτηκαν πάνω από 14.700 εργαστηριακά επιβεβαιωμένα κρούσματα ιλαράς σε 13 χώρες της αμερικανικής ηπείρου και δεκάδες θάνατοι: πρόκειται για «σχεδόν 32πλάσιο» επίπεδο από αυτό του 2024, ανέφερε ο διευθυντής του ΠΑΟΥ Ζάρμπας Μπαρμπόσα, κατά τη διάρκεια συνέντευξης Τύπου.
«Η τάση αυτή συνεχίζεται το 2026 και επιταχύνεται», καθώς πλέον τα κρούσματα είναι «πάνω από 15.300», κυρίως στο Μεξικό, στη Γουατεμάλα, στις ΗΠΑ και στον Καναδά, τόνισε.
«Η επανεμφάνιση της ιλαράς στην αμερικανική ήπειρο αποτελεί σημαντικό πισωγύρισμα, που όμως είναι εντελώς αναστρέψιμο» χάρη στον εμβολιασμό, σημείωσε.
Η ιλαρά έχει κύρια συμπτώματα πυρετό, καταρροή, βήχα, επιπεφυκίτιδα, φωτοφοβία και εξανθήματα στο πρόσωπο, στον κορμό και στα άκρα.
Ενώ τα εμβόλια κατά της ιλαράς είναι εξαιρετικά αποτελεσματικά κι έχουν λάβει άδειες, σε χώρες όπου πιστευόταν ότι η νόσος είχε εξαλειφθεί, η αύξηση των αμφισβητήσεων για τα εμβόλια και οι δυσκολίες ως προς την πρόσβαση στα εμβόλια σε κάποιες σήμαναν πως το πεδίο έγινε εύφορο για την επανεμφάνιση και την εξάπλωση της νόσου.
«Μεταδίδεται μέσω του αέρα και εξαπλώνεται πολύ εύκολα»
«Ο κόσμος ξέχασε. Επειδή δεν βλέπει πλέον επιδημίες σε μαζική κλίμακα και παιδιά να πεθαίνουν γύρω του, αμφιβάλλει γιατί να κάνει εμβόλια, αλλά η ιλαρά ουδέποτε εξαλείφθηκε (παγκοσμίως), όπως η ερυθρά, κι όταν ο ιός αυτός μολύνει κάποιον ευάλωτο, του επιτίθεται ανελέητα», επέμεινε ο Ντανιέλ Σάλας, αρμόδιος για τα προγράμματα εμβολιασμού στον ΠΑΟΥ, στο Γαλλικό Πρακτορείο.
Με αυτό το φόντο, και καθώς πλέον πλησιάζει στον ορίζοντα το Μουντιάλ του 2026, που θα διεξαχθεί στις ΗΠΑ, στο Μεξικό και στον Καναδά, όπου ο ιός κυκλοφορεί, ο γιατρός κάλεσε τους τουρίστες να φροντίσουν να είναι επαρκώς εμβολιασμένοι και να πάρουν προφυλάξεις για να αποφύγουν μολύνσεις.
Σχεδόν επτά εκατομμύρια επισκέπτες αναμένονται στις 16 πόλεις όπου θα διεξαχθούν αγώνες αυτής της διοργάνωσης, κάθε άλλο παρά συνηθισμένης, καθώς για πρώτη φορά θα πρόκειται για τουρνουά με 48 ομάδες και 104 αγώνες. Πέρα από τον κόσμο που θα υποδεχθεί στα στάδια, η καθεμιά από τις πόλεις αυτές θα οργανώσει «φεστιβάλ φιλάθλων», όπου θα συρρέουν χιλιάδες υποστηρικτές για να παρακολουθήσουν τα ματς σε γιγαντιαίες οθόνες.
«Η ιλαρά είναι νόσος που μεταδίδεται μέσω του αέρα και εξαπλώνεται πολύ εύκολα. Ο ιός μπορεί ακόμη και να σταθεί στον αέρα για ως και δυο ώρες αφού κάποιος μολυσμένος άνθρωπος φύγει από κάποιον χώρο», θύμισε, σύμφωνα με το ΑΠΕ-ΜΠΕ
Όταν επικοινώνησε μαζί του το Γαλλικό Πρακτορείο, το αμερικανικό υπουργείο Υγείας -επικεφαλής του οποίου είναι σήμερα μορφή των αντιεμβολιαστών, που επικρίνεται για τον τρόπο με τον οποίο χειρίστηκε την επιδημία ιλαράς- ανέφερε πως βρίσκεται σε «συντονισμό με τους ομοσπονδιακούς εταίρους του» και εργάζεται «σε στενή συνεργασία με τη FIFA και τοπικούς παράγοντες για να εγγυηθεί την υγεία και την ασφάλεια των Αμερικανών και των ξένων επισκεπτών κατά τη διάρκεια του Παγκοσμίου Κυπέλλου» ποδοσφαίρου (Ιούνιος-Ιούλιος).